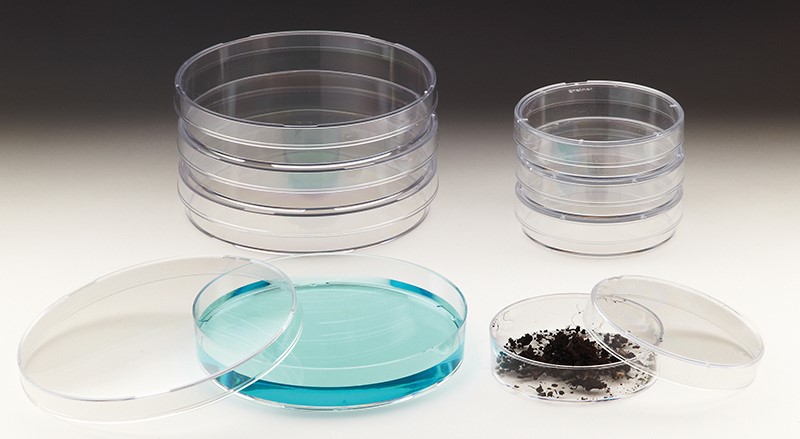
Petrischale aus Polystyrol 60x15mm

Produkte filtern
–
Produkte anzeigan
Produkte filtern
–
Produkte anzeigan
Mikrobiologie
Sortierung: